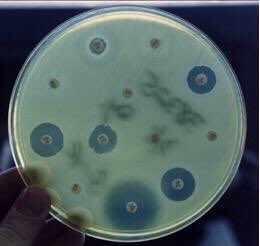

٤- بين جينر وفليمنج كانت المصادفة، والمغامرة جزءاً من التجريب. ولكنّ ثمّ عاملٌ مشترك أقوى، وهو قوّة الملاحظة، وحسن الربط بين الملاحظات والنتائج.المؤكّد أن الكثير في القرية كان يعرف أنّ من يُصب بجدري البقر لا يصابُ بالجدري. ولكنّ جينر وحدهُ استنتج العلاقة وغامر.
يتبع..
يتبع..
٦- هنا رابط لموضوع مقاومة المضادات الحيوية في موقع منظمة الصحة العالمية لمن يحب الاطلاع.
who.int
who.int
٧- و في محاولة لتقصي تاريخ الأوبئة الحديث في الدولة، وبينما العالم الغربي يتخلص من الجدري، رصدت الحالات في الجزيرة العربية و بعضها في ساحل الإمارات المتصالحة إلى قبيل الاتحاد، حيث تشير الوثائق البريطانية لوجود حالات الجدري في الساحل الشرقي.
يتبع..
يتبع..
جاري تحميل الاقتراحات...